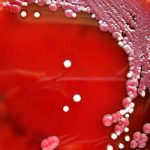
4 bebés murieron en Italia a causa de una bacteria italia

Etiqueta: medidas de higiene
Consejos de salud en Nicaragua: si estás resfriado, usa mascarilla en el bus
En esta temporada de invierno, las familias de Nicaragua deben poner en práctica las medidas de seguridad para prevenir enfermedades respiratorias y gastrointestinales.
En este...
4 bebés murieron en Italia a causa de una bacteria
Tras las denuncias de algunos padres, una investigación desveló que fue una bacteria, la Citrobacter, que se encontraba en uno de los grifos de...
Rumanía reabrirá el lunes sus fronteras al tráfico rodado y ferroviario
Rumanía reabrirá el próximo lunes sus fronteras al tráfico ferroviario y por carretera, anunció este jueves el presidente de Rumanía, Klaus Iohannis, al presentar...
Granada: Red de Comunicadores realizó ameno torneo de videojuegos
La tarde de este sábado 2 de mayo, la Red de Comunicadores de la Juventud Sandinista, en la ciudad de Granada, desarrolló el primer...
¿Cuánto cuestan las mascarillas contra el Covid-19 en América Latina?
El uso de las mascarillas no es suficiente para evitar el contagio del nuevo brote de coronavirus, si no se acompaña de las debidas...
Alerta por «Coxsackie» brote en la piel que afecta a niñez de Costa Rica
El Ministerio de Salud de Costa Rica emitió una alerta sobre el aumento de casos de menores de cinco años que presentan la presencia...